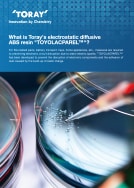

- HOME
- White paper download
White paper download
What is Toray’s electrostatic diffusive ABS resin TOYOLACPAREL™?
For 5G-related parts, battery transport trays, home appliances, etc., measures are required to preventing electronic circuit disruption due to static electric sparks. TOYOLACPAREL™ has been developed to prevent the disruption of electronic components and the adhesion of dust caused by the build-up of static charge.
Contents
- Increased antistatic needs (electrostatic diffusivity)
- Disadvantages of conventional antistatic technology for resin
- What is electrostatic diffusible ABS resin "TOYOLACPAREL™"?
- Introduction example